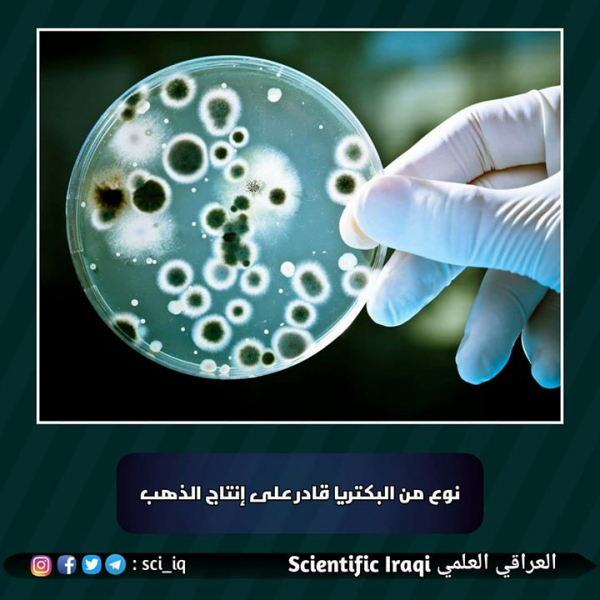

1556 مشاهدة
2
0
هنالك نوع من البكتريا تستطيع امتصاص المركبات الكيميائية الغنية بالمعادن السامة لاستخراج الذهب منها ثم إنتاج شذرات صغيرة من الذهب، كيف تتم هذه العملية؟
إكتشاف نوع من البكتريا قادر على إنتاج الذهب !• هنالك نوع من البكتريا تستطيع امتصاص المركبات الكيميائية الغنية بالمعادن السامة لأستخراج الذهب منها ثم إنتاج شذرات صغيرة من الذهب
• تسمى هذه البكتريا بـ (كوبريافيدوس ميتاليدورانز) التي تعيش في العناصر السامة الغنية بالمعادن
• قام مجموعه من الباحثين بدراسة العمليات الجزيئيّة التي تسمح لهذه البكتريا بالإبداع البيولوجي للذهب وكان كل ذلك يتعلق بكيفية التعامل مع النحاس والذهب في التربة
• كـُل من النحاس والذهب سام بكمية كبيرة ولكن تطورت وتكيفت البكتريا لأحتياج النحاس من أجل النجاة ، التربة التي تحتوي على هذه البكتريا تكون غنية بالمعادن الثقيلة السامة التي تحولها البكتريا إلى شكل يسهل التعامل معه ،إذا كان هناك الكثير من النحاس فإن البكتريا سوف تفعل أنزيم خاص يسمى (كاب اي-cupA) الذي يضخ النحاس الزائد ويبقي البكتريا صحية
• كما هناك شيء غريب حصل عندما يكون الذهب موجوداً ، مركبات الذهب والنحاس سامة جداً ، إذاً البكتريا تحتاج لحماية نفسها ، للقيام بذلك يتم جعل أنزيم (كوب أي ) غير نشط وإنزيم مختلف غيره يسمى (كب اي-copA) ينشط بدلاً عنه ، هذا الانزيم يعمل على تحويل مركبات الذهب والنحاس إلى شكل يكون من الصعب امتصاصه
• هذا يؤكد إن عدد أقل من مركبات الذهب والنحاس تدخل إلى الجوف الخلوي وأوضح "نيس" إن البكتريا تتسمم بشكل قليل وإن الإنزيم الذي يضخ النحاس يمكن أن يتخلص من النحاس الزائد دون عراقيل ، وهنالك نتيجة اخرى هي :- المركبات الذهبية التي يصعب إمتصاصها تتحول في المنطقة الخارجية من الخلية الى شذرات ذهبية غير ضارة فقط تساوي بضعة نانومتر بالحجم
• هذه البكتريا مسؤولة عن إيداع الذهب الثانوي الذي ينبع من إنهيار خامات الذهب القديمة التي تم إنشاؤها جيولوجيا في الأرض .
ترجمة : مارشل علي
تعديل لغوي : مهدي أحمد
تصميم : محمد علي احمد
#العراقي_العلمي
نشر في 03 آذار 2018

تابع
متابع
تابع
متابع
تابع
متابع
تابع
متابع
تابع
متابع
تابع
متابع
تابع
متابع

 أديان
أديان علوم
علوم منوع
منوع ثقافة
ثقافة أدبيات
أدبيات تاريخ وجغرافيا
تاريخ وجغرافيا تقني
تقني